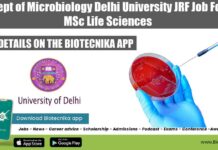
Dept of Microbiology Delhi University JRF Job For MSc Life Sciences Delhi University Vacancy 2022

Sanofi Scientific Writer Job Opening For Life Sciences, Apply Online
Sanofi Scientific Writer Job Opening For Life Sciences, Apply Online
Sanofi Scientific Writer Job Opening For Life Sciences, Apply Online. MSc, PhD job at Sanofi....
NCCS Pune Multiple Project Vacancies 2022 – Online Application Process
NCCS Pune 2022 Vacancies - SRF & Project Jobs Available
NCCS Pune 2022 Vacancies - SRF & Project Jobs Available. NCCS Pune Recruitment 2022. NCCS...
IIT Gandhinagar PhD Admission 2022-23 Biological Engineering
IIT Gandhinagar Admission 2022-23 PhD Biological Engineering
IIT Gandhinagar Admission 2022-23 PhD Biological Engineering. IIT Gandhinagar PhD Admission 2022-23 Biological Engineering. Check out all the...
CSIR-CFTRI MSc Biotech, Microbiology, Food Science & Food Technology Project Job
CFTRI Project Opening Available - MSc Biotech, Microbiology Apply Online
CFTRI Project Opening Available - MSc Biotech, Microbiology Apply Online. CSIR-CFTRI Job Opening. MSc Biotech,...
NIBMG MSc Life Sciences Project Assistant Recruitment, Apply Online
NIBMG Project Job Opening For MSc Life Sciences, Apply Online
NIBMG Project Job Opening For MSc Life Sciences, Apply Online. MSc Life Sciences job. Interested...
IISc-MCBL MSc & PhD Biotech, Life Sciences Project Vacancies, Applications Invited
IISc Project Jobs 2022 For MSc & PhD Biotech, Life Sciences
IISc Project Jobs 2022 For MSc & PhD Biotech, Life Sciences. Indian Institute of...
CUET (UG) 2022 Results Declared – Check & Download Score Card
CUET UG 2022 Results Declared - Check & Download Score Card
PRESS RELEASE
16 Septemeber 2022
Sub: - NTA Declares the Result/NTA Scores of Common University Entrance...
Biotecnika Times Newsletter 15.09.2022 CCMB Admissions 2023, NIBMG, IMTECH
Biotecnika Times Newsletter CCMB Admissions 2023, NIBMG, IMTECH
CCMB January 2023 PhD Program Admission – Online Application Process
CCMB PhD Admission 2023 January – Apply Online....
Panjab University MSc & MTech Life Sciences Project Assistant Recruitment
Panjab University Project Vacancy For MSc & MTech Life Sciences
Panjab University Project Vacancy For MSc & MTech Life Sciences. Candidates with MSc & MTech Biotechnology,...
Medpace BSc Life Sciences Data Coordinator Job, Apply Online
Medpace BSc Life Sciences Data Coordinator Job, Apply Online
Medpace BSc Life Sciences Data Coordinator Job, Apply Online. Data Coordinator - Core Laboratory vacancy for...
CSIR-IMTECH MSc Bioinformatics Project Associate Job, Apply Online
IMTECH Bioinformatics Project Opening For MSc Candidates, Apply Online
IMTECH Bioinformatics Project Opening For MSc Candidates, Apply Online. Project Associate Recruitment. Interested and eligible applicants...
NCBS STEM Cell Program Manager Job For PhD Life Sciences, Apply Online
NCBS PhD Jobs 2022 For Life Sciences, Apply Online
NCBS PhD Jobs 2022 For Life Sciences, Apply Online. PhD Life Sciences Program Manager job opening....
TERI Project Job For MSc & MTech – 0-2 Exp Candidates Apply
TERI Project Job For MSc & MTech - 0-2 Exp Candidates Apply
TERI Project Job For MSc & MTech - 0-2 Exp Candidates Apply. Interested...
NIBMG Genomic Surveillance Jobs For MSc, BTech, MTech & PhD Biotech, Biophysics, Bioinformatics
NIBMG Research Jobs Latest For BTech, MSc, MTech & PhD
NIBMG Research Jobs Latest For BTech, MSc, MTech & PhD. BTech, MTech, MSc & PhD...
NII Agricultural Science Project Associate Recruitment, Applications Invited
NII Agricultural Science Project Job Opening, Applications Invited
NII Project SRF Posting For MSc Biological Sciences. MSc Natural/Agricultural Sciences Project Associate Job opening. Interested and...